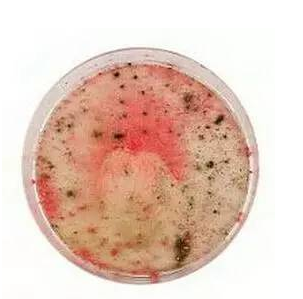
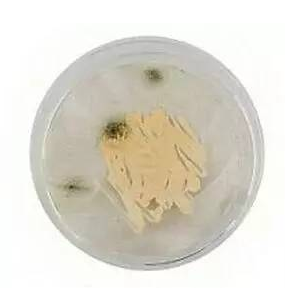

舊化妝品捨不得丟?別小氣了!它們可能藏匿著細菌,有的還能夠引起危及生命的腦膜炎!
四分之一的女性,一隻睫毛膏會使用一年。

但睫毛膏9個月就會過保質期
五分之一的女性,
一瓶潔面乳用12個月

但這是建議使用期限的兩倍
還有十分之一的人,
口紅會用上超過三年!

其實兩年就已經超過保質期了...
倫敦城市大學的研究人員測試了五種產品,包括腮紅、粉底和唇彩。他們竟然發現了五種致命細菌!
真桿菌——會導致細菌性陰道炎
氣單胞菌屬——會導致腸胃炎和傷口感染
表皮葡萄球菌——一種會對抗生素產生耐藥性的細菌,對本身有疾病的人來說可能會致命
痤瘡丙酸菌屬——是導致痤瘡和其他皮膚問題的主要原因
腸桿菌屬——對於免疫係統受損的人來說,可能引起泌尿係統和呼吸道感染

唇膏
放置兩年11個月(過期10個月)
檢測呈腦膜炎細菌陽性

睫毛膏
放置10個月(過期4個月)
檢測呈腸桿菌屬和真桿菌陽性
腮紅
放置1年10個月(過期9個月)
檢測發現腦膜炎細菌陽性

唇彩放置1年(2016年8月過期)
檢測呈腦膜炎細菌陽性
粉底
放置1年5個月(過期4個月)
檢測呈腦膜炎細菌陽性
英國倫敦城市大學這項對5000名女性展開的調查顯示,20%女性的化妝品會留五年以上,但這存在血液中毒、泌尿道感染和腸胃炎的風險。
在測試腮紅、粉底和唇彩等5種化妝品後,研究人員在這些化妝品上發現了糞腸球菌——腦膜炎的主要致病原因之一。
測試中還發現其他潛在致命細菌,包括真桿菌,其能夠導致細菌性陰道炎。另外還有氣單胞菌屬,這是導致腸胃炎和傷口感染的原因之一。
| sponsored ads |
|
|
| sponsored ads |

此外,研究人員還發現了表皮葡萄球菌,其對抗生素和丙酸桿菌有抗藥性。而丙酸桿菌是導致痤瘡和其他皮膚問題的主要原因之一。
測試結果顯示,這些化妝品上還藏有導致泌尿道和呼吸道感染的腸桿菌。

凱蒂·迪拉德,LiB集團的首席運營官說:「我們化妝包裡都有一件或兩件不尋常的化妝品,但很明顯這項調查顯示,很多女性也會留著她們不怎麼用的物品。」

一、不要同時使用多個廠家的產品。擦抹不同廠家生產的化妝品,在人體肌膚上容易引起化學反應。
| sponsored ads |
|
|
| sponsored ads |
一般說來,最好是選擇同一廠家生產的係列化妝品。
二、不要使用已過保質期的化妝品。化妝品中很多成分時間長了就會分解、變化,極易引起皮膚損傷。
三、不要過量使用化妝品。因皮膚有其自身的代謝規律,過厚的脂粉會堵塞毛孔,影響皮膚的正常呼吸。
四、不要過分追求療效,警惕這些化妝品可能含有激素。按規定,現在的化妝品都需要詳細標註所含的成分,常見的標有“松”的成分,通常表示含有激素。
五、不要迷信天然產品,天然產品也有致敏感的成分。
| sponsored ads |
|
|
| sponsored ads |
六、不要用手指摸化妝品。化妝工具要勤洗勤換,如果不注意衛生,就會引起化學反應而導致化妝品的變質。
|